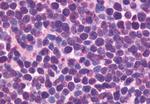
CXCR5 Antibody in Immunohistochemistry (Paraffin) (IHC (P))

Search
Invitrogen
CXCR5 Polyclonal Antibody
{{$productOrderCtrl.translations['antibody.pdp.commerceCard.promotion.promotions']}}
{{$productOrderCtrl.translations['antibody.pdp.commerceCard.promotion.viewpromo']}}
{{$productOrderCtrl.translations['antibody.pdp.commerceCard.promotion.promocode']}}: {{promo.promoCode}} {{promo.promoTitle}} {{promo.promoDescription}}. {{$productOrderCtrl.translations['antibody.pdp.commerceCard.promotion.learnmore']}}
产品信息
PA5-33458
种属反应
宿主/亚型
分类
类型
抗原
偶联物
形式
浓度
规格
纯化类型
保存液
内含物
保存条件
运输条件
RRID
产品详细信息
Percent identity with other species by BLAST analysis: Human, Gorilla, Gibbon, Monkey (100%) Mouse, Rat, Dog, Bovine, Hamster, Panda, Rabbit, Pig (94%).
靶标信息
CD185, also known as CXCR5 or Burkitt lymphoma receptor 1 (BLR1), is a seven-transmembrane G protein-coupled receptor in the CXC chemokine receptor family. It plays a crucial role in lymphocyte trafficking, particularly in T cell migration into B cell follicles of germinal centers in response to CXCL13, making it a key marker of follicular helper T cells. In peripheral blood, CXCR5 is expressed on B cells, CD4+ T cells (excluding Th1 and Th2 cells), and a subset of memory (CD45RO+) T cells. These CD185+ T cells are in a resting state and migrate to lymph nodes due to CCR7 and CD62L expression. In tonsils, CD185 is found on nearly all CD4+ cells, along with activation markers like CD69 and ICOS, and can induce antibody production when co-cultured with B cells. CXCR5 is expressed in lymphatic tissues such as lymph node follicles and the spleen, and is also found in human blood and salivary glands, as well as various animal tissues. It is essential for B cell migration and is part of the larger family of G protein-coupled receptors (GPCRs), which have seven membrane-spanning helices and are involved in numerous signaling pathways. GPCRs, including CXCR5, are regulated by various ligands that affect their conformation and signaling through G-proteins and downstream effectors. The regulation of GPCRs, including their deactivation, has significant implications for cellular functions and is a major focus of pharmacological research, leading to the development of drugs like Zyprexa and Claritin for mental health and allergy treatments.
仅用于科研。不用于诊断过程。未经明确授权不得转售。
篇参考文献 (0)
生物信息学
蛋白别名: Blr-1; Burkitt lymphoma receptor 1; Burkitt lymphoma receptor 1, GTP binding protein (chemokine (C-X-C motif) receptor 5); Burkitt lymphoma receptor 1, GTP-binding protein; C Cmotif chemokine; C X C motif chemokine; C-X-C chemokine receptor type 5; CC motif chemokine; CCmotif chemokine; CD185; CD185 antigen; chemokine (C-X-C motif) receptor 5; CXC; CXC motif chemokine; CXC-R5; CXCR-5; Fusin; GPR9; HUMSTR; LESTR; MDR-15; Monocyte-derived receptor 15; unnamed protein product
基因别名: BLR1; CD185; CXCR5; MDR15
UniProt ID: (Human) P32302
Entrez Gene ID: (Human) 643